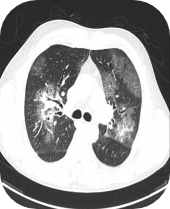

Results

Chest computerised tomography (CT):
Bronchosapirate culture:
Bronchoalveolar lavage (BAL) culture:
BAL galactomannan:
Calcofluor white staining:
Bilateral ground glass opacities and a small
consolidation in the left lower lung lobe
consolidation in the left lower lung lobe


Aspergillus niger
Aspergillus niger - 6000 colony-forming
units CFU/mL
units CFU/mL
Aspergillus fumigatus
Aspergillus fumigatus - 1000 CFU/mL
Positive for filamentous
fungal elements
fungal elements
Images supplied with permission of treating clinician.
5.709 (OI > 10.0)